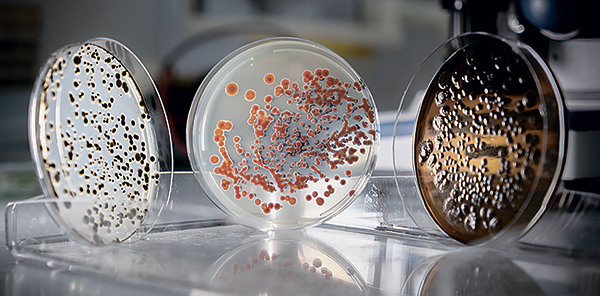
Микробный консорциум для жизни на Марсе

У астрономов климат иной
Современные астрономические инструменты — вещь очень сложная и дорогая, с их помощью астрономы способны заглянуть далеко во Вселенную и увидеть то, что и не снилось их предшественникам.

В этом номере:

Современные астрономические инструменты — вещь очень сложная и дорогая, с их помощью астрономы способны заглянуть далеко во Вселенную и увидеть то, что и не снилось их предшественникам.

Нанопроволоками называют проволоки диаметром менее 100 нм. Интерес к ним вызван общим движением в сторону миниатюризации техники.

Открытие в 2004 году графена — листа углерода толщиной всего в один атом — ознаменовало новую эру в материаловедении.

Химики из Великобритании и Италии проанализировали осадок на дне бронзового кувшина, найденного в 1954 году при раскопках захоронения на месте древнего города Пестум.

Современные искусственные ноги и руки так соединены с нервной системой человека, что не просто двигаются, но и обладают определённым осязанием.

Давайте присмотримся к едва ли не самым незаметным и самым древним сухопутным представителям растительного мира — мохообразным.
Человечество не оставляет идею марсианских садов и шаг за шагом движется к этой цели.

Среди городских птиц чаще всего мы видим голубей и воробьёв, но этим птичий мир в городе не ограничивается.

Возобновляемые источники энергии чаще всего ассоциируются с ветром, солнцем, гидроресурсами и теплом земных недр. Однако в возобновляемой энергетике есть ещё одна важная область — биоэнергетика.

В конце ноября 2025 года состоялся четырнадцатый Национальный суперкомпьютерный форум (НСКФ-25).

На территории Дагестанского заповедника (Республика Дагестан) есть знаменитая ландшафтная достопримечательность — бархан Сарыкум, одна из крупнейших песчаных дюн Евразии.

Соя, на которую льёт зной солнце, относится к числу древнейших культур мирового земледелия. Она прошла длинный путь от скромного дикорастущего растения до одной из самых ценных сельскохозяйственных культур.

Наш мир полон звуков. Любое движение, будь то явление неживой природы или проявление чьей-то деятельности, порождает в окружающей среде механические колебания, которые и называют звуками.

Используя цифры 2, 0, 2, 6 (цифры можно группировать в числа) и знаки математических операций, получить ряд натуральных чисел от 1 до 20.

Вода — удивительно коварная жидкость. Тёплая, когда течёт из крана на кухне, она легко разрывает толстые стальные трубы, если ей стало холодно и она замёрзла.

В центре крымского города Керчь возвышается «гора» Митридат. На самом деле это холм — он всего 92 м в высоту, но керчане издавна называют родные холмы горами.

Диалектологами XIX—XX веков было зафиксировано множество значений слова «зюзя». Например, в западных и южных землях европейской части России зюзей называли холод, мороз, стужу.

История введения в культуру этого североамериканского вида насчитывает почти четыреста лет. Это история мучений, привыкания и, наконец, победного шествия по городам, сёлам и лесополосам всего евразийского континента.

Вместе с Гердой я всматриваюсь в зелёную бугорчатую голограмму, висящую над столом. Она состоит из циферок, интегралов, непонятных значков, чёрточек, загогулин и прочей математической мутотени.

Моя бабушка, всю жизнь прожившая на Волге, частенько употребляла это смешное сочетание — хундры-мундры, имея в виду всякие мелочи, личные вещи или, как порой говорят, «нехитрый скарб».

Самое древнее кафе Италии Antico Caffe Greco находится в Риме, оно открылось в 1760 году.

Хотим попросить вас помочь нам определить грызуна, которого сфотографировал наш постоянный автор Олег Алексеевич Першин.

Захлестнула волна отзывов о журнале. Хочу высказать и своё мнение (безусловно, у каждого будет своя правда, свои пристрастия и любимые или нелюбимые рубрики).

Микроводоросли содержат большое количество ценных биологически активных веществ, в том числе антиоксидантов.

Ботаническими изысканиями можно заняться и в зимнее время, изучая то, что доступно, — деревья и кустарники. Кто-то может возразить: нет ни цветков, ни листьев, одни ветки…
